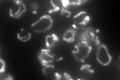
YKL016C
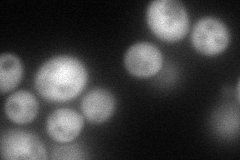
YKL016C
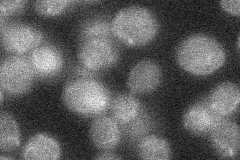
YKL016C
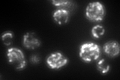
YKL016C
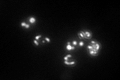
YKL016C

View description
Subunit d of the stator stalk of mitochondrial F1F0 ATP synthase, which is a large, evolutionarily conserved enzyme complex required for ATP synthesis
Localization:
Intensity:
Fold change:
Significance:
-
C’ GFP library in SD
mitochondria120.82 -
N' NOP1pr-GFP in SD
cytosol111.509 -
N' TEF2pr-mCherry in SD

vacuoleN/A -
N' NATIVEpr-GFP in SD
below threshold20.5728 -
N' TEF2pr-VC and Cyto-VN in SD

#N/A0 -
C’ GFP library in SD+DTT
mitochondria145.111.2No -
C’ GFP library in SD+H2O2

mitochondria77.350.64Yes -
C’ GFP library in Starvation Media
mitochondria152.91.26No -
C’ GFP library on the background of Pup2-DaMP

mitochondria -
C’ GFP library on the background of CCT mutant

mitochondria71.64560.592951Yes
